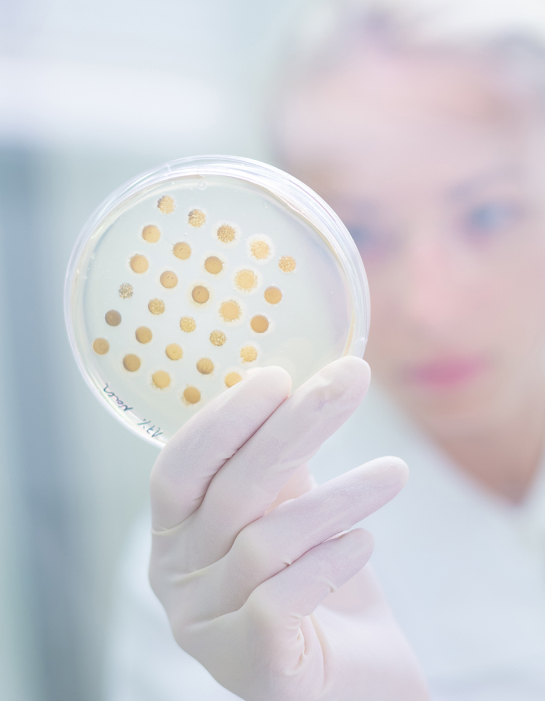

이즈솔루션은 필름이란 소재에 세포 배양 및 유체칩 개발의 선두 주자로
2010년도부터 유수의 대학/기관/병원/기업에 대한 기술지원 및 신기술 개발 지원으로 유체칩의 기술 집약도를 높이는데 탁월한 기술을 가지고 있습니다.
십여 년 이상의 노하우를 통해 시행착오 없이 개발진행에 노하우를 공유드리고 제품의 특성과 성능을 높이는데 기여하도록 하겠습니다.
- 국내
- 서울대학교/고려대학교/연세대학교/국민대학교/한양대학교/서강대학교/성균관대학교/가톨릭대학교/카이스트 외
- 국외
- MIT/싱가폴 난양공대 외
- 병원
- 서울대학병원/ 삼성서울병원/삼성의료원/성모병원/대구경북과학기술원 외
국내·외 유수 기업들과도 파트너쉽을 맺고 기술지원을 하고 있습니다.
앞으로도 많은 관심 부탁드립니다.